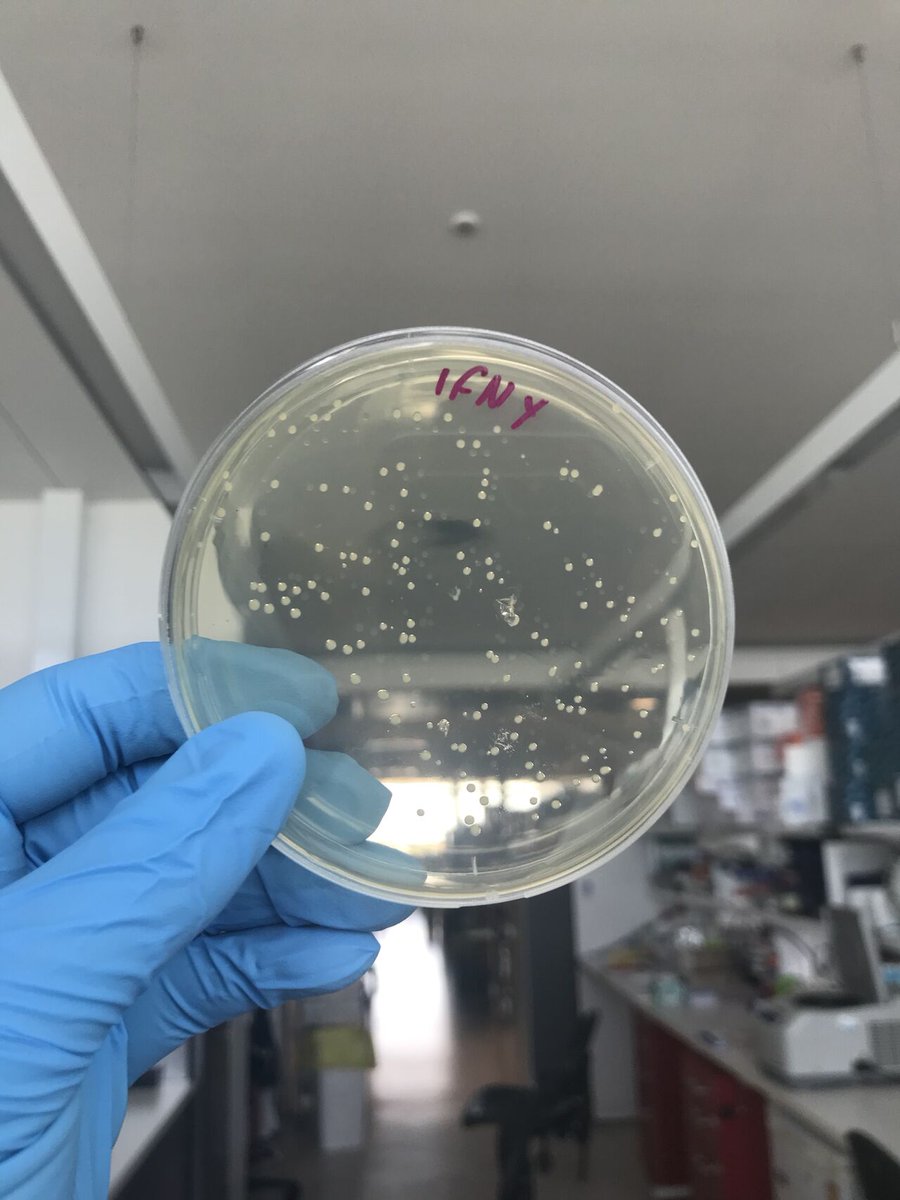
BioZoneUWA tweet media

Even more excitingly, collaboration between Assistant Professor @nano_jenn and @IanLChin has enabled a much closer look into peptide-cell interactions through use of gold nano-particle technology.
#BioZone #UWA #WomenInSTEM
GIF
English
BioZoneUWA
174 posts

@BioZoneUWA
BioZone researchers use a transdisciplinary approach to biomedical research to solve complex challenges, leading to improved patient care.

Aboriginal kids have a high rate of chronic ear infections - yet they may have to wait up to 2.5 years to see a specialist. The Telethon Kids Ear Portal program aims to reduce wait times by involving community-based Aboriginal health workers in assessments bit.ly/2QGWpXk